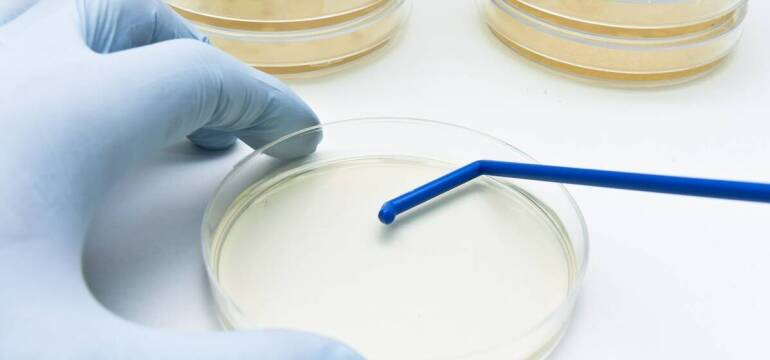
a0aa032b-58f2-4206-ab21-56896e5ddbe8.jpg

Badanie moczu na posiew odgrywa istotną rolę w diagnostyce mikrobiologicznej, umożliwiając identyfikację patogenów odpowiedzialnych za infekcje układu moczowego. Analiza próbki pozwala lekarzom na dokładne określenie rodzaju bakterii lub grzybów, co jest niezbędne do wdrożenia odpowiedniego leczenia. Dia-Bakter oferuje profesjonalne usługi w zakresie badań laboratoryjnych, wspierając tym samym proces diagnozowania i leczenia pacjentów w Białymstoku.
Procedura badania moczu na posiew
Badanie moczu na posiew rozpoczyna się od przygotowania próbki, która powinna być pobrana zgodnie z zaleceniami lekarza. Następnie materiał trafia do laboratorium, gdzie specjaliści przeprowadzają odpowiednie analizy. W przypadku badania moczu na posiew istotne są czynniki wpływające na wyniki, takie jak czas od pobrania próbki czy stosowane leki. Dlatego ważne jest przestrzeganie zaleceń dotyczących przygotowania i pobrania materiału. Wyniki badań pozwalają na identyfikację obecnych w moczu bakterii i grzybów oraz ocenę ich wrażliwości na antybiotyki. Dzięki temu lekarz może dobrać odpowiednią terapię, co ma znaczenie dla skuteczności leczenia oraz uniknięcia powikłań. Dia-Bakter Diagnostyka Laboratoryjna Mikrobiologia Katarzyna Leszczyńska to placówka oferująca szeroki zakres badań mikrobiologicznych, w tym analizę moczu na posiew, morfologię krwi oraz badania serologiczne i alergologiczne.
Wskazania do badania moczu na posiew
Badanie moczu na posiew jest zalecane w różnych sytuacjach klinicznych, szczególnie gdy istnieje podejrzenie zakażenia dróg moczowych. Może być również wykonane u pacjentów z nawracającymi infekcjami lub niewłaściwą odpowiedzią na leczenie. Wskazania obejmują także ocenę skuteczności terapii antybiotykowej oraz diagnostykę przed zabiegami chirurgicznymi. Grupy osób, które mogą skorzystać z tego badania, to dorośli, dzieci oraz kobiety w ciąży. W przypadku ciężarnych celem analizy jest monitorowanie stanu zdrowia matki i dziecka oraz zapobieganie powikłaniom związanym z infekcjami dróg moczowych. Dia-Bakter Diagnostyka oferuje pełen zakres usług związanych z badaniem moczu oraz innymi analizami laboratoryjnymi.
Rola badania moczu na posiew w diagnostyce
Analiza moczu na posiew ma kluczowe znaczenie w diagnozowaniu i terapii schorzeń układu moczowego, umożliwiając wykrycie drobnoustrojów oraz ocenę ich reakcji na leki. Informacje te są istotne dla lekarzy przy wyborze odpowiedniej terapii, co może prowadzić do szybszej poprawy stanu zdrowia pacjenta. Należy jednak pamiętać o potencjalnych ograniczeniach tego badania, takich jak trudności w uzyskaniu próbki czy błędy laboratoryjne. Wyniki powinny być interpretowane w kontekście innych badań oraz objawów klinicznych.